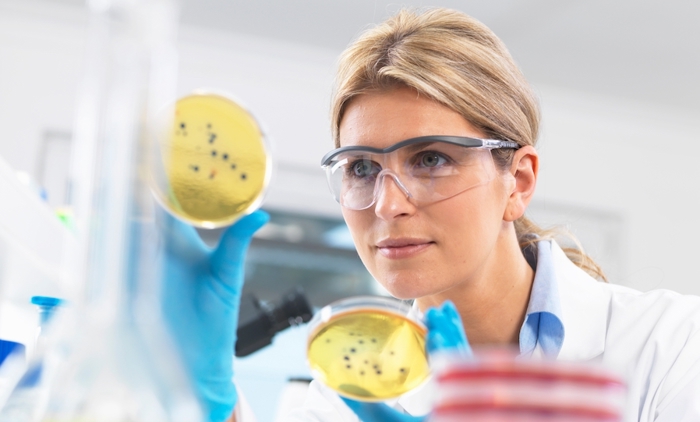
Scientist with bacteria plates.

Do different types of dogs come from mutations or natural genetic variability?
January 27, 2006

- Related Topics:
- Genetic variation,
- Population genetics,
- Evolution,
- Mutation
A curious adult from Texas asks:
"I am having a debate with a friend about mutations and natural genetic variation. I say that the only way an ancestral population of canines could give rise to foxes, wolves, coyotes, and all varieties of dogs is through mutations and either natural or artificial selection.
This is a tricky question because the difference between the two arguments is such a subtle one. And yet, it has such profound implications.
Basically, you are both right. This is because genetic variation comes from past mutations. Even as we speak, more diversity is being added to the world's DNA through new DNA changes. But it is important to note that the natural variation we already have can lead to a whole lot of differences within a species.
Random sorting can produce some variation. For example, think about the differences between you and your siblings. Almost all of these differences don't come from new mutations.
The same is true for dogs. It turns out that a lot of the genetic variation in dogs today came from variation that existed in their wolf ancestors.1 What that means is that a lot of the genetic differences between a Chihuahua and a Great Dane were already there.
But we don’t know for sure if those ancient genetic variations are entirely responsible for the huge physical differences between the two breeds. New mutations can and do happen, after all.
To give a solid answer, we would need to know more about the genetics of each breed. What genetic difference (or differences) causes a Great Dane to be so large? Or a Chihuahua to have a round head? Even though scientists are making progress figuring these things out, there’s still a lot we don’t know.1
In any case, it’s just a question of when specific mutations happened. All that natural genetic variation in wolves came from mutations as well. So whether a specific genetic difference in your Golden Retriever was inherited from a distant wolf ancestor or a more recent dog ancestor, it came from a past mutation.

Mutations and genetic variation
First off, mutations can and do happen all of the time. Even if everything were on Earth for only 10,000 years, if you compared the DNA from then to the DNA now, there would be lots of differences.
The evidence for DNA mutation is all around us. A sad example is cancer — all cancer is the result of DNA mutation.
But obviously not all mutations lead to cancer. In fact, we are all born with over 100 new mutations that our parents didn’t have.2 And some of these can be passed down to our own children.
So if someone 1000 years from now were to analyze their DNA, there would be many mutations that were not there before. When scientists look at the DNA of different species, they see this kind of evidence. This is natural variation as a result of mutation.
These mutations aren't anything special; they're just the result of being alive. For example, things in the environment like the foods we eat or sunlight can cause mutations.
Another source of mutation is in our cells. When a cell divides into two new cells, it needs to copy all 6 billion letters of DNA. And the cell isn't perfect — it makes mistakes sometimes.
A lot of these mistakes are repaired but a few aren't. These few are a source of new mutations.
And if they happen early on or are in the sperm or egg cells, the mutation will be passed on to the next generation. The end result of all of this is added genetic variation through mutations.

How mutations make new traits
Do we have any experiments that show that new mutations result in a new trait? Something where a new trait doesn't come from the mixing and matching of what is already there? Yes, there are a lot of experiments like this.
One of my favorites is discussed in Kenneth Miller's book, Finding Darwin's God. A scientist named Barry Hall showed that bacteria could gain the ability to grow on the sugar found in milk (lactose) because of new mutations.3
Some bacteria already have a system for using lactose to grow. The system is pretty amazing and intricate.
It consists of three genes: one that helps get the lactose in, one that turns the lactose into simpler sugars that the bacteria can use, and a gene that keeps all of these genes off when no lactose is around.
What Barry Hall did was to damage this system in a bacterium and then asked it to grow on lactose. Now there isn't any natural variability here.
The experiment starts with a single bacterium with a single sequence of DNA. And this single bacterium could not use lactose to grow.
Over time, some of this original bacterium's "children" developed the ability to use lactose for food. When scientists looked at the DNA of these bacteria, the results were astonishing.
There were two separate mutations that were not there before that allowed for the bacteria to live on lactose. Now I won't get into the fight about whether this is evidence for evolution or not. But it is certainly evidence that mutations can and do happen and that new traits can arise from more than the natural genetic variability that we all start out with.
Mutations in humans
In essence, we are a collection of our past mutations. We continue to have new mutations as a species. Most won't have any effect, some will be harmful, and some will be useful.
And some won't be useful until something in the environment changes. Drinking milk as an adult is an example.
Most mammals can't do it but around 25% of people can tolerate milk as an adult. Evidence suggests that one of the mutations arose well before adults started to drink milk.
The DNA mutation just passed from generation to generation not being used. Then, suddenly, it was an advantage to be able to drink milk during cold, dark winters.
Now people who could drink milk were healthier and had more babies. The mutation became more common and continues to do so to this day.
This example shows why it is so hard to distinguish between natural variation and mutation. Is the milk example a mutation or variation? It is both.

Author: Dr. D. Barry Starr
Barry served as The Tech Geneticist from 2002-2018. He founded Ask-a-Geneticist, answered thousands of questions submitted by people from all around the world, and oversaw and edited all articles published during his tenure. AAG is part of the Stanford at The Tech program, which brings Stanford scientists to The Tech to answer questions for this site, as well as to run science activities with visitors at The Tech Interactive in downtown San Jose.
 Skip Navigation
Skip Navigation
